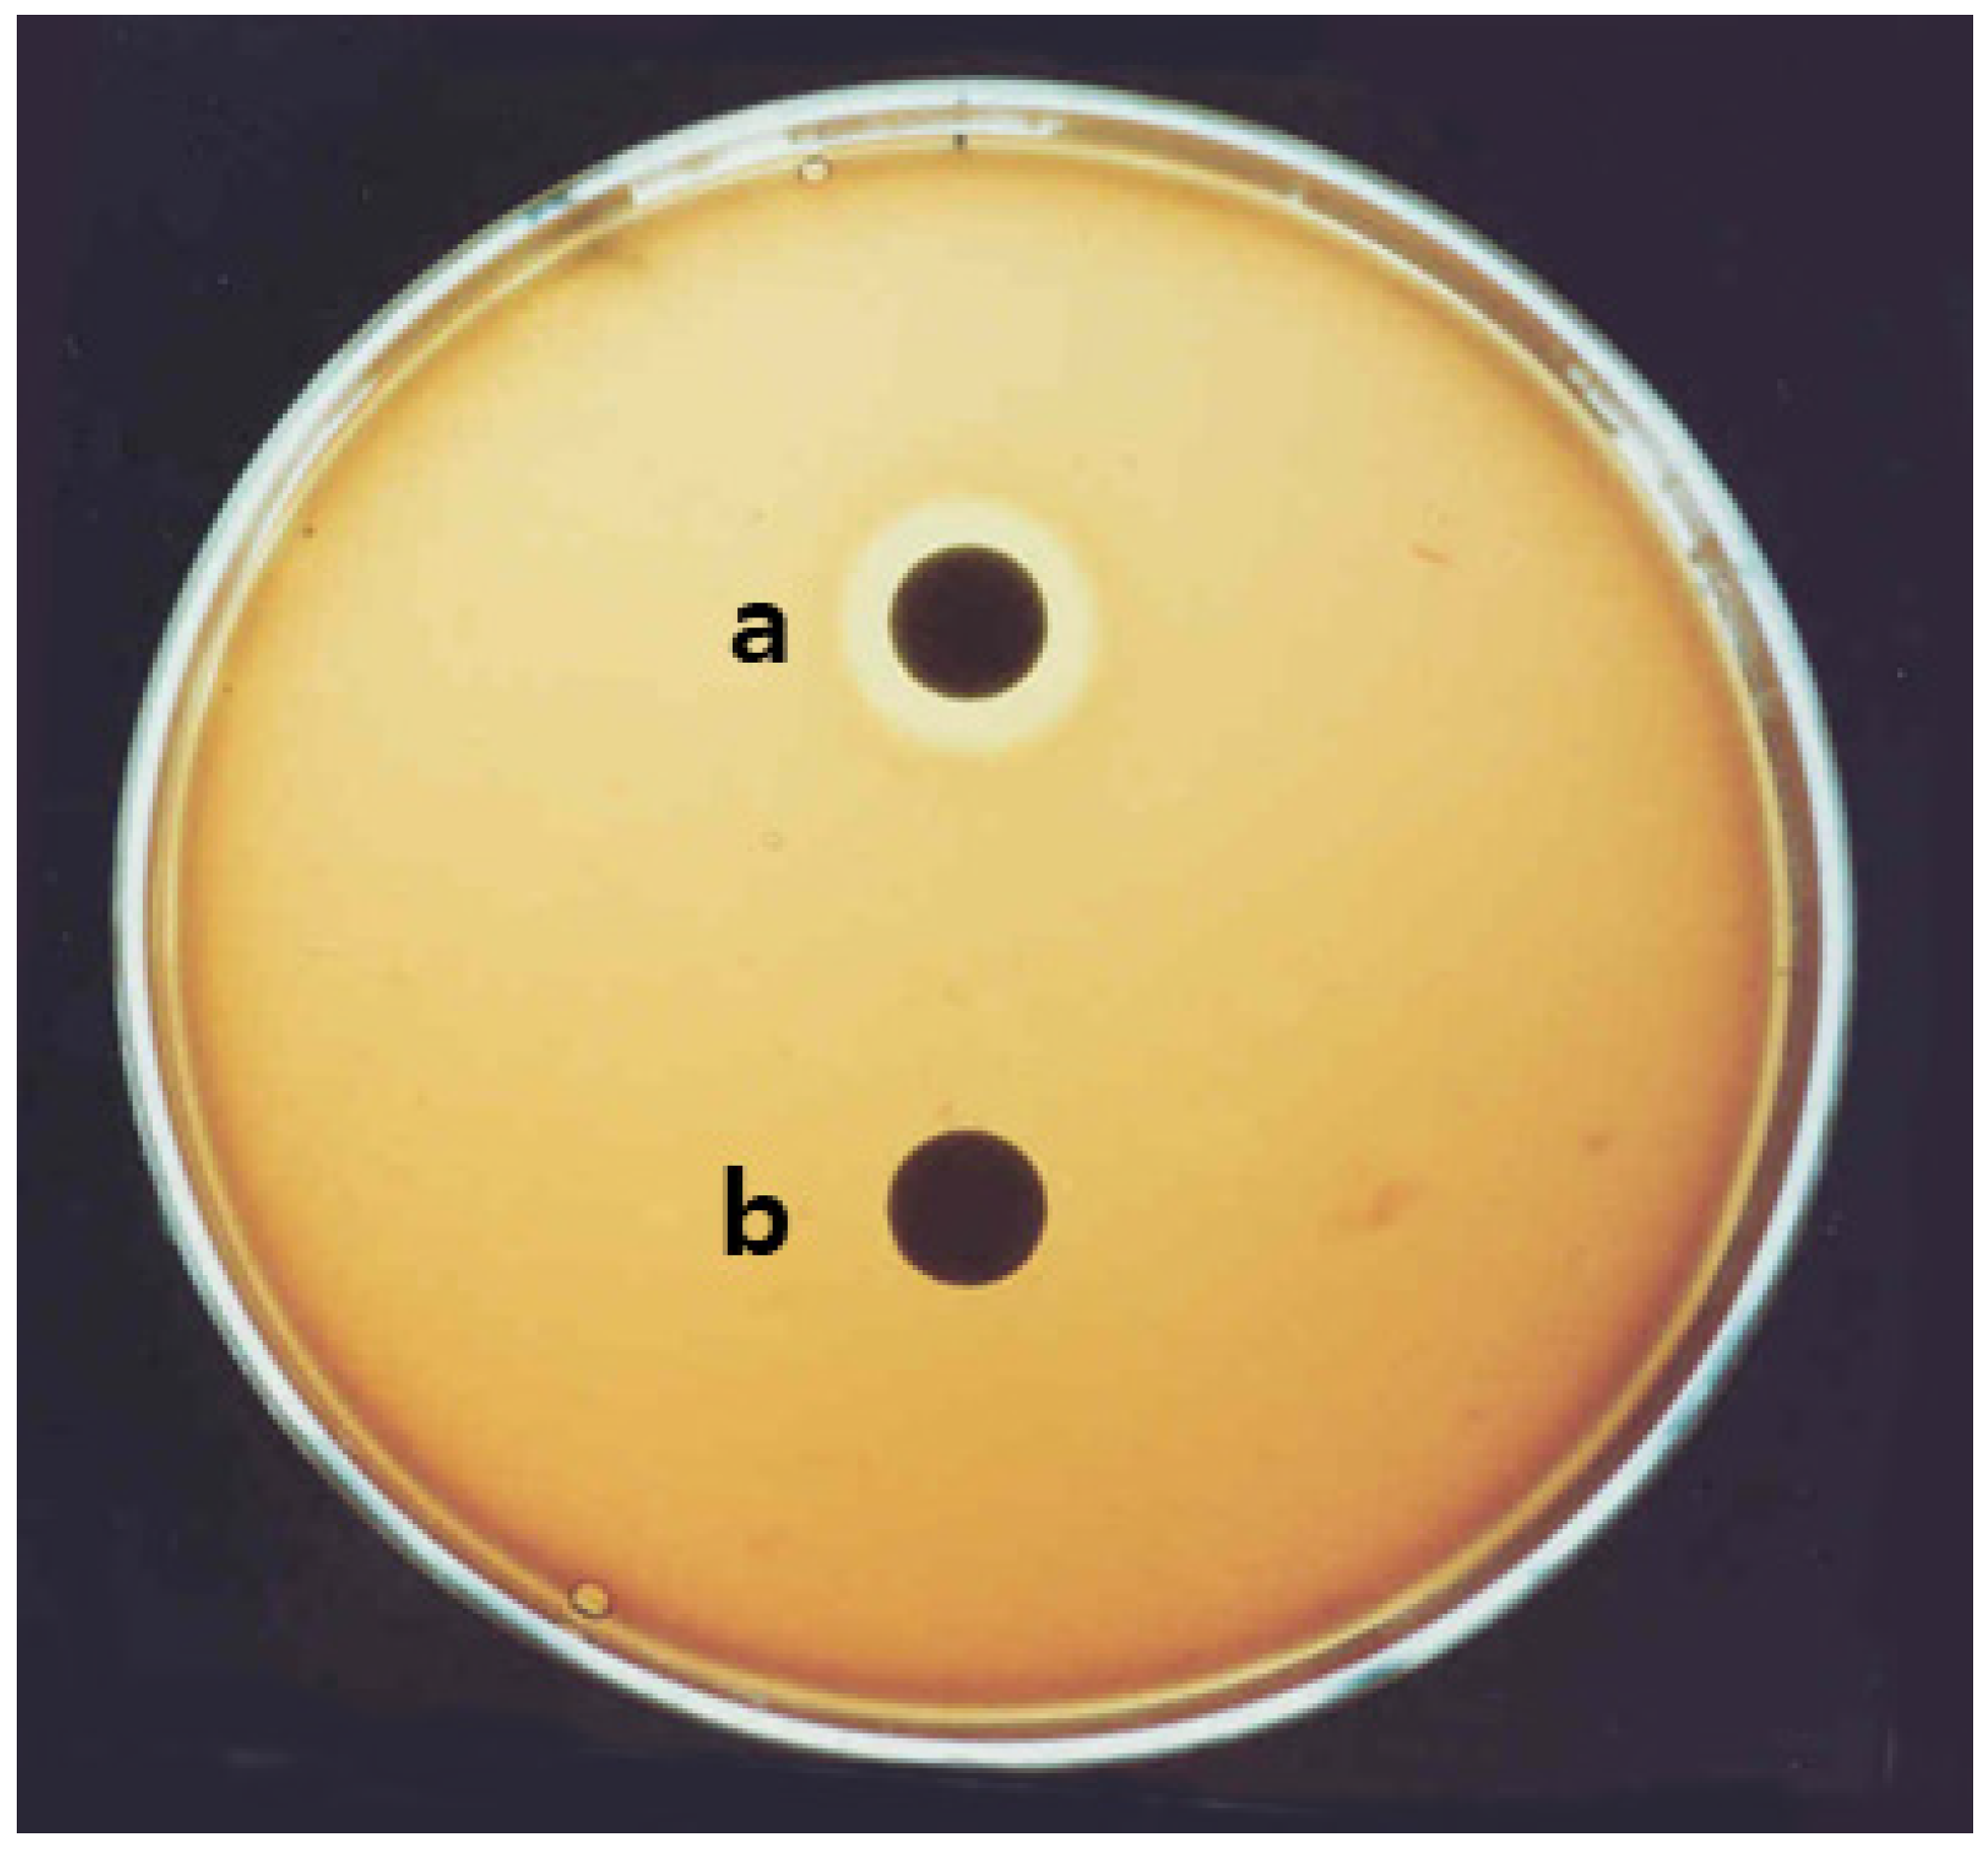
Molecules 26 04478 g001 550

Five Surfactin Isomers Produced during Cheonggukjang Fermentation by Bacillus pumilus HY1 and Their Properties
Abstract
:1. Introduction
2. Results
2.1. Isolation of Surfactin from B. pumilus HY1
2.2. Mass Spectrum of Surfactin by B. pumilus HY1
2.3. Changes in Viable Cell Number of B. pumilus HY1 and Surfactin Concentration during Cheonggukjang Fermentation
2.4. Effect of MSIC on the Growth of Cancer Cells
3. Discussion
4. Materials and Methods
4.1. Soybean, Media, Cells, and Regents
4.2. Indentification of HY1 Strain, and Isolation and Purification of Surfactin
4.3. Mass Spectrometric Analysis of Surfactin Isoforms
4.4. Amino Acid and Mineral Analysis
4.5. Preparation and Fermentation of Cheonggukjang
4.6. Extraction and Analysis of Surfactin
4.7. MTT Assay
5. Conclusions
Author Contributions
Funding
Informed Consent Statement
Data Availability Statement
Conflicts of Interest
Sample Availability
Abbreviations
| CLP | cyclic lipopeptide |
| MSIC | mixture of five surfactin isoforms of cheonggukjang |
| TS | tryptic soy |
| No. 3 | number 3 |
| MTT | 3-(4,5-dimethylthiazol-2-yl)-2,5-diphenyltetrazolium bromide |
| EDTA | ethylenediaminetetraacetic acid |
| DMSO | dimethyl sulfoxide |
| FBS | fetal bovine serum |
| MALDI-TOF MS | matrix-assisted laser desorption ionization time-of-flight mass spectrometry |
| ESI-MS/MS | electrospray ionization tandem mass spectrometry |
| HPLC | high performance liquid chromatography |
References
- From, C.; Hormazabal, V.; Hardy, S.P.; Granum, P.E. Cytotoxicity in Bacillus mojavensis is abolished following loss of surfactin synthesis: Implications for assessment of toxicity and food poisoning potential. Int. J. Food Microbiol. 2007, 117, 43–49. [Google Scholar] [CrossRef]
- Kalinovskaya, N.I.; Kuznetsova, T.A.; Ivanova, E.P.; Romanenko, L.A.; Voinov, V.G.; Huth, F.; Laatsch, H. Characterization of surfactin-like cyclic depsipeptides synthesized by Bacillus pumilus from ascidian Halocynthia aurantium. Mar. Biotechnol. 2002, 4, 179–188. [Google Scholar] [CrossRef] [PubMed]
- Koumoutsi, A.; Chen, X.H.; Henne, A.; Liesegang, H.; Hitzeroth, G.; Franke, P.; Vater, J.; Borriss, R. Structural and functional characterization of gene clusters directing nonribosomal synthesis of bioactive cyclic lipopeptides in Bacillus amyloliquefaciens strain FZB42. J. Bacteriol. 2004, 186, 1084–1096. [Google Scholar] [CrossRef] [PubMed] [Green Version]
- Lee, J.H.; Nam, S.H.; Seo, W.T.; Yun, H.D.; Hong, S.Y.; Kim, M.K.; Cho, K.M. The production of surfactin during the fermentation of cheonggukjang by potential probiotic Bacillus subtilis CSY191 and the resultant growth suppression of MCF-7 human breast cancer cells. Food Chem. 2012, 131, 1347–1354. [Google Scholar] [CrossRef]
- Thaniyavarn, J.; Roongsawang, N.; Kameyama, T.; Haruki, M.; Imanaka, T.; Morikawa, M.; Kanaya, S. Production and characterization of biosurfactants from Bacillus licheniformis F2.2. Biosci. Biotechnol. Biochem. 2003, 67, 1239–1244. [Google Scholar] [CrossRef]
- Schwarzer, D.; Finking, R.; Marahiel, M.A. Nonribosomal peptides: From genes to products. Nat. Prod. Rep. 2003, 20, 275–287. [Google Scholar] [CrossRef]
- Li, H.; Gilchrist, C.L.M.; Phan, C.S.; Lacey, H.J.; Vuong, D.; Moggach, S.A.; Lacey, E.; Piggott, A.M.; Chooi, Y.H. Biosynthesis of a new benzazepine alkaloid nanangelenin a from Aspergillus nanangensis involves an unusual l-kynurenine-incorporating NRPS catalyzing regioselective lactamization. J. Am. Chem. Soc. 2020, 142, 7145–7152. [Google Scholar] [CrossRef]
- Dose, B.; Ross, C.; Niehs, S.P.; Scherlach, K.; Bauer, J.P.; Hertweck, C. Food-poisoning bacteria employ a citrate synthase and a type II NRPS to synthesize bolaamphiphilic lipopeptide antibiotics. Angew. Chem. Int. Ed. 2020, 59, 21535–21540. [Google Scholar] [CrossRef]
- Niehs, S.P.; Dose, B.; Richter, S.; Pidot, S.; Dahse, H.M.; Stinear, T.P.; Hertweck, C. Mining symbionts of a spider-transmitted fungus illuminates uncharted biosynthetic pathways to cytotoxic benzolactones. Angew. Chem. Int. Ed. 2020, 59, 7766–7771. [Google Scholar] [CrossRef] [PubMed] [Green Version]
- Symmank, H.; Franke, P.; Saenger, W.; Bernhard, F. Modification of biologically active peptides: Production of a novel lipohexapeptide after engineering of Bacillus subtilis surfactin synthetase. Protein Eng. 2002, 15, 913–921. [Google Scholar] [CrossRef]
- Hue, N.; Serani, L.; Laprevote, O. Structural investigation of cyclic peptidolipids from Bacillus subtilis by high-energy tandem mass spectrometry. Rapid Commun. Mass Spectrom. 2001, 15, 203–209. [Google Scholar] [CrossRef]
- Kameda, Y.; Oira, S.; Matsui, K.; Kanatomo, S.; Hase, T. Antitumor activity of Bacillus natto. V. Isolation and characterization of surfactin in the culture medium of Bacillus natto KMD 2311. Chem. Pharm. Bull. 1974, 22, 938–944. [Google Scholar] [CrossRef] [Green Version]
- Kim, K.M.; Lee, J.Y.; Kim, C.K.; Kang, J.S. Isolation and characterization of surfactin produced by Bacillus polyfermenticus KJS-2. Arch. Pharm. Res. 2009, 32, 711–715. [Google Scholar] [CrossRef] [PubMed]
- Vollenbroich, D.; Ozel, M.; Vater, J.; Kamp, R.M.; Pauli, G. Mechanism of inactivation of enveloped viruses by the biosurfactant surfactin from Bacillus subtilis. Biologicals 1997, 25, 289–297. [Google Scholar] [CrossRef]
- Tsukagoshi, N.; Tamura, G.; Arima, K. A novel protoplast bursting factor (surfactin) obtained from Bacillus subtilis IAM1213. I. The effects of surfactin on Bacilllus megaterium KM. Biochim. Biophys. Acta 1970, 196, 204–210. [Google Scholar] [CrossRef]
- Hwang, M.H.; Chang, Z.Q.; Kang, E.H.; Lim, J.H.; Yun, H.I.; Rhee, M.H.; Jeong, K.S.; Park, S.C. Surfactin C inhibits Mycoplasma hyopneumoniae-induced transcription of proinflammtory cytokines and nitric oxide production in murin RAW 264.7 cells. Biotechnol. Lett. 2008, 30, 229–233. [Google Scholar] [CrossRef]
- Morán, A.C.; Martínez, M.A.; Siñeriz, F. Quantification of surfactin in culture supernatants by hemolytic activity. Biotechnol. Lett. 2002, 24, 177–180. [Google Scholar] [CrossRef]
- Kikuchi, T.; Hasumi, K. Enhancement of plasminogen activation by surfactin C: Augmentation of fibrinolysis in vitro and in vivo. Biochim. Biophys. Acta 2002, 29, 234–245. [Google Scholar] [CrossRef]
- Arima, K.; Kakinuma, A.; Tamura, G. Surfactin, a crystalline peptide lipid surfactant produced by Bacillus subtilis: Isolation, characterization and its inhibition of fibrin clot formation. Biochem. Biophys. Res. Commun. 1968, 31, 488–494. [Google Scholar] [CrossRef]
- Hosono, K.; Suzuki, H. Acylpeptides, the inhibition of cyclic adenosine 3′,5′ monophosphate phosphodiesterase. III. Inhibition of cyclic AMP phosphodiesterase. J. Antibiot. 1983, 36, 679–683. [Google Scholar] [CrossRef] [Green Version]
- Kim, K.; Jung, S.Y.; Lee, D.K.; Jung, J.; Park, J.K.; Kim, D.K.; Lee, C. Suppression of inflammatory responses by surfactin, a selective inhibitor of platelet cytosolic phospholipase A2. Biochem. Pharmacol. 1998, 55, 975–985. [Google Scholar] [CrossRef]
- Cho, K.M.; Hong, S.Y.; Math, R.K.; Lee, J.H.; Kambiranda, D.M.; Kim, J.M.; Islam, S.M.A.; Yun, M.G.; Cho, J.J.; Lim, W.J.; et al. Biotransformation of phenolics (isoflavones, flavanols and phenolic acids) during the fermentation of cheonggukjang by Bacillus pumilus HY1. Food Chem. 2009, 114, 413–419. [Google Scholar] [CrossRef]
- Cho, K.M.; Lee, J.H.; Yun, H.D.; Ahn, B.Y.; Kim, H.; Seo, W.T. Changes of phytochemical constituents (isoflavones, flavanols, and phenolic acids) during cheonggukjang soybeans fermentation using potential probiotics Bacillus subtilis CS90. J. Food Compost. Anal. 2011, 24, 402–410. [Google Scholar] [CrossRef]
- Cho, K.M.; Math, R.K.; Hong, S.Y.; Islam, S.M.A.; Mandanna, D.K.; Cho, J.J.; Yun, M.G.; Kim, J.M.; Yun, H.D. Iturin produced by Bacillus pumilus HY1 from Korean soybean sauce (kanjang) inhibits of aflatoxin producing fungi. Food Cont. 2009, 20, 402–406. [Google Scholar] [CrossRef]
- Baumgart, F.; Kluge, C.; Ullrich, B.; Vater, J.; Ziessow, D. Identification of amino acid substitutions in the lipopeptide surfactin using 2D NMR spectroscopy. Biochem. Biophys. Res. Commun. 1991, 177, 998–1005. [Google Scholar] [CrossRef]
- Vallet, M.; Vanbellingen, Q.P.; Fu, T.; Caer, J.P.L.; Della-Negra, S.; Touboul, D.; Duncan, K.R.; Nay, B.; Brunelle, A.; Prado, S. An integrative approach to decipher the chemical antagonism between the competing endophytes Paraconiothyrium varialbile and Bacillus subtilis. J. Nat. Prod. 2017, 80, 2863–2873. [Google Scholar] [CrossRef] [Green Version]
- Zhu, Z.; Zhang, F.; Wei, Z.; Ran, W.; Shen, Q. The usage of rice straw as a major substrate for the production of surfactin by Bacillus amyloliquefaciens XZ-173 in solid-state fermentation. J. Environ. Manag. 2013, 127, 96–102. [Google Scholar] [CrossRef] [PubMed]
- Heerklotz, H.; Seelig, J. Leakage and lysis of lipid membranes induced by the lipopeptide surfactin. Eur. Biophys. J. 2006, 35, 305–314. [Google Scholar] [CrossRef] [PubMed] [Green Version]
- Meta, M.; Yang, S.H.; Bergo, M.O.; Fong, L.G.; Young, S.G. Protein farnesyltransferase inhibitors and progeria. Trends Mol. Med. 2006, 12, 480–487. [Google Scholar] [CrossRef] [PubMed]
- Kamada, T.; Kang, M.C.; Phan, C.S.; Zanil, I.I.; Jeon, Y.J.; Vairappan, C.S. Bioactive cembranoids from the soft coral genus Sinularia sp. in Borneo. Mar. Drugs 2018, 16, 99. [Google Scholar] [CrossRef] [Green Version]
- Yamakami, Y.; Kensuke, K.; Yonekura, R.; Kudo, I.; Fujii, M.; Ayusawa, D. Molecular basis for premature senescence induced by surfactants in normal human cells. Biosci. Biotechnol. Biochem. 2014, 78, 2022–2029. [Google Scholar] [CrossRef] [PubMed] [Green Version]
- Zhao, H.; Yan, L.; Xu, X.; Jiang, C.; Shi, J.; Zhang, Y.; Liu, L.; Lei, S.; Shao, D.; Huang, Q. Potential of Bacillus subtilis lipopeptides in anti-cancer I: Induction of apoptosis and paraptosis and inhibition of autophagy in K562 cells. AMB Express 2018, 8, 78. [Google Scholar] [CrossRef]
- Cao, X.H.; Wang, A.H.; Wang, C.L.; Mao, D.Z.; Lu, M.F.; Cui, Y.Q.; Jiao, R.Z. Surfactin induces apoptosis in human breast cancer MCF-7 cells through a ROS/JNK-mediated mitochondrial/caspase pathway. Chem. Biol. Interact. 2010, 183, 357–362. [Google Scholar] [CrossRef]
- Wakamatsu, Y.; Zhao, X.; Jin, C.; Day, N.; Shibahara, M.; Nomura, N. Manno-sylerythritol lipid induces characteristics of neuronal differentiation in PC12 cells through an ERK-related signal cascade. Eur. J. Biochem. 2001, 268, 374–383. [Google Scholar] [CrossRef] [PubMed]
- Sudo, T.; Zhao, X.; Wakamatsu, Y.; Shibahara, M.; Nakahara, T. Induction of the differentiation of human HL-60 promyelocytic leukemia cell line by succinoyl trehalose lipids. Cytotechnology 2000, 33, 259–264. [Google Scholar] [CrossRef]
- Wang, C.L.; Ng, T.B.; Yuan, F.; Liu, Z.K.; Liu, F. Induction of apoptosis in human leukemia K562 cells by cyclic lipopeptide from Bacillus subtilis natto T-2. Peptides 2007, 28, 1344–1350. [Google Scholar] [CrossRef]
- Cao, X.H.; Wang, A.H.; Jiao, R.Z.; Wang, C.L.; Mao, D.Z.; Yan, L.; Zeng, B. Surfactin induces apoptosis and G2/M arrest in human breast cancer MCF-7 cells through cell cycle factor regulation. Cell Biochem. Biophys. 2009, 55, 163–171. [Google Scholar] [CrossRef]
- Ohno, A.; Ano, T.; Shoda, M. Production of a lipopeptide antibiotic surfactin with recombinant Bacillus subtilis. Biotechnol. Lett. 1992, 14, 1165–1168. [Google Scholar] [CrossRef]
- Slvinski, C.T.; Mallmann, E.; de Araújo, J.M.; Mitchell, D.A.; Krieger, N. Production of surfactin by Bacillus pumilus UFPEDA 448 in solid-state fermentation using medium based on okara with sugarcane bagasse as a bulking agent. Proc. Biochem. 2012, 47, 1848–1855. [Google Scholar] [CrossRef] [Green Version]
- Cho, S.J.; Hong, S.Y.; Kim, J.Y.; Park, S.R.; Kim, M.K.; Lim, W.J.; Shin, E.C.; Kim, E.J.; Cho, Y.U.; Yun, H.D. Endophytic Bacillus sp. CY22 from a balloon flower (Platycodon grandiflorum) produces surfactin isoforms. J. Microbiol. Biotechnol. 2003, 13, 859–865. [Google Scholar]

| Elements | Concentration (ppb) | Elements | Concentration (ppb) |
|---|---|---|---|
| Al | 0.0 | P | 1121.5 |
| B | 133.6 | Rb | 0.0 |
| Br | 0.0 | Re | 0.0 |
| Ca | 1509.6 | Ru | 94.4 |
| Cd | 0.0 | S | 348,218.9 |
| Cr | 122,736.5 | Sc | 74,514.2 |
| Cs | 0.0 | Se | 1,112,974.3 |
| Cu | 0.0 | Sn | 115.1 |
| Ge | 194.9 | Sr | 0.0 |
| Hg | 26.9 | Ta | 2.9 |
| I | 1375.0 | Ti | 580.2 |
| K | 89.4 | U | 0.0 |
| Li | 122.4 | V | 0.0 |
| Mg | 5634.3 | W | 44.7 |
| Mn | 0.0 | Y | 538.1 |
| Mo | 0.0 | Yb | 0.0 |
| Na | 6446.2 | Zn | 2351.4 |
| Os | 0.0 |
Publisher’s Note: MDPI stays neutral with regard to jurisdictional claims in published maps and institutional affiliations. |
© 2021 by the authors. Licensee MDPI, Basel, Switzerland. This article is an open access article distributed under the terms and conditions of the Creative Commons Attribution (CC BY) license (https://creativecommons.org/licenses/by/4.0/).
Share and Cite
Hong, S.-Y.; Lee, D.-H.; Lee, J.-H.; Haque, M.A.; Cho, K.-M. Five Surfactin Isomers Produced during Cheonggukjang Fermentation by Bacillus pumilus HY1 and Their Properties. Molecules 2021, 26, 4478. https://doi.org/10.3390/molecules26154478
Hong S-Y, Lee D-H, Lee J-H, Haque MA, Cho K-M. Five Surfactin Isomers Produced during Cheonggukjang Fermentation by Bacillus pumilus HY1 and Their Properties. Molecules. 2021; 26(15):4478. https://doi.org/10.3390/molecules26154478
Chicago/Turabian StyleHong, Su-Young, Dong-Hee Lee, Jin-Hwan Lee, Md. Azizul Haque, and Kye-Man Cho. 2021. "Five Surfactin Isomers Produced during Cheonggukjang Fermentation by Bacillus pumilus HY1 and Their Properties" Molecules 26, no. 15: 4478. https://doi.org/10.3390/molecules26154478
APA StyleHong, S.-Y., Lee, D.-H., Lee, J.-H., Haque, M. A., & Cho, K.-M. (2021). Five Surfactin Isomers Produced during Cheonggukjang Fermentation by Bacillus pumilus HY1 and Their Properties. Molecules, 26(15), 4478. https://doi.org/10.3390/molecules26154478
